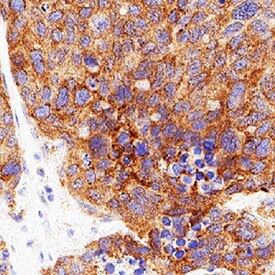

376 results for "Thrombopoietin/Tpo" in 产品
Thrombopoietin/Tpo Products
Thrombopoietin (Tpo), is a key regulator of megakaryocytopoiesis and thrombopoiesis. It is principally produced in the liver and is bound and internalized by the receptor Tpo R/c-mpl. Defects in the Tpo-Tpo R signaling pathway are associated with a variety of platelet disorders. Tpo promotes the differentiation, proliferation, and maturation of megakaryocytes and their progenitors. Tpo additionally promotes platelet production, aggregation, ECM adhesion, and activation. Aside from its hematopoietic effects, Tpo is expressed in the brain where it promotes the apoptosis of hypoxia-sensitized neurons and inhibits neuronal differentiation by blocking NGF-induced signaling.
| Reactivity: | Human |
Build your own Luminex Assay with our Luminex Assay Customization Tool
| Reactivity: | Human |
| Source: | NS0 |
| Accession #: | P40225 |
| Applications: | Bioactivity |
| Reactivity: | Human |
| Sensitivity: | 18.5 pg/mL |
| Assay Range: | 31.2-2000 pg/mL (Cell Culture Supernates, Serum, EDTA Plasma, Heparin Plasma) |
| Applications: | ELISA |
Animal Free
| Reactivity: | Human |
| Source: | E. coli |
| Accession #: | NP_000451.1 |
| Applications: | Bioactivity |
| Reactivity: | Mouse |
| Source: | NS0 |
| Accession #: | P40226 |
| Applications: | Bioactivity |
| Reactivity: | Mouse |
| Sensitivity: | 20 pg/mL |
| Assay Range: | 62.5-4000 pg/mL (Cell Culture Supernates, Serum, EDTA Plasma, Citrate Plasma) |
| Applications: | ELISA |
Contains 4 membranes-each spotted in duplicate with 111 different cytokine antibodies
| Reactivity: | Mouse |
| Reactivity: | Human |
| Source: | E. coli |
| Accession #: | NP_000451 |
| Applications: | Bioactivity |
Build your own Human Cytokine Premixed Luminex Performance Assay using our custom ordering tool. Earn double rewards for reviews
| Reactivity: | Human |
Build your own Luminex Assay with our Luminex Assay Customization Tool
| Reactivity: | Mouse, Rat |
| Details: | Goat IgG Polyclonal |
| Applications: | WB, B/N |
| Reactivity: | Human |
| Details: | Goat IgG Polyclonal |
| Applications: | WB, B/N |
| Reactivity: | Human |
| Details: | Rabbit IgG Polyclonal |
| Applications: | WB, ELISA |
| Reactivity: | Human |
| Source: | E. coli |
| Accession #: | NP_000451.1 |
| Applications: | Bioactivity |
For use with catalog number DTP00B
| Reactivity: | Human |
| Applications: | ELISA, Ctrl |
| Reactivity: | Human |
| Source: | Sf 21 (baculovirus) |
| Accession #: | P40225 |
| Applications: | Bioactivity |
| Reactivity: | Mouse |
| Assay Range: | 62.5-4000 pg/mL |
| Applications: | ELISA |
| Reactivity: | Human |
| Details: | Mouse IgG2B Monoclonal Clone #34817 |
| Applications: | ELISA(Cap), B/N |
| Reactivity: | Human |
| Source: | E. coli |
| Accession #: | NP_000451.1 |
| Applications: | Bioactivity |
| Reactivity: | Mouse |
| Details: | Rat IgG2A Monoclonal Clone #378120 |
| Applications: | WB, ELISA(Cap) |
Analyzed by SEC-MALS. His-tag (HEK-293-expressed)
| Reactivity: | Human |
| Source: | HEK293 |
| Accession #: | P40225.1 |
| Applications: | Bioactivity |
| Reactivity: | Human |
| Source: | E. coli |
| Accession #: | NP_000451.1 |
| Applications: | Bioactivity |
| Reactivity: | Human |
| Details: | Mouse IgG1 Monoclonal Clone #34863 |
| Applications: | WB |
| Reactivity: | Human |
| Details: | Mouse IgG1 Monoclonal Clone #1065103 |
| Applications: | WB |
| Reactivity: | Human |
| Details: | Mouse IgG1 Monoclonal Clone #1053909 |
| Applications: | IHC |
| Reactivity: | Human |
| Assay Range: | 93.8-6000 pg/mL |
| Applications: | ELISA |














![Western Blot: Thrombopoietin/THPO Antibody [NBP1-59293] Western Blot: Thrombopoietin/THPO Antibody [NBP1-59293]](https://resources.rndsystems.com/images/products/Thrombopoietin-Antibody-Western-Blot-NBP1-59293-img0002.jpg)